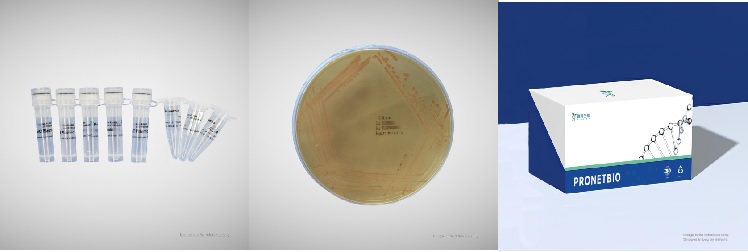

AI Bio 소식
[공식 대리점] [Pronetbio] - Yeast Two-Hybrid (Nuclear System) Vector Kit 효모 이중 하이브리드 (핵 시스템) 벡터 키트(RY8008)
- AI바이오허브 오래 전 2025.01.25 00:04 Bulletin Board 인기
-
790
0
Pronetbio
Yeast Two-Hybrid (Nuclear System) Vector Kit
효모 이중 하이브리드 (핵 시스템) 벡터 키트(RY8008)
CAT: RY8008
The Yeast Two-Hybrid (Nuclear System) Vector Kit (RY8008) is specifically designed for performing yeast-based nuclear protein two-hybrid library screening and one-to-one interaction validation. This kit supports both cotransformation and mating methods and includes all essential components for efficient experiments.
효모 이중 하이브리드 (핵 시스템) 벡터 키트(RY8008)는 효모 기반 핵 단백질 이중 하이브리드 라이브러리 스크리닝 및 일대일 상호작용 검증을 수행하도록 설계되었습니다. 이 키트는 공동 형질전환(co-transformation) 및 교배(mating) 방식을 모두 지원하며, 효율적인 실험을 위해 필수 구성 요소를 모두 포함하고 있습니다.
Key features:
Product Components
Component | Name | Specification | Quantity |
Plasmid | pGADT7 | 100 ng/μL | 20 μL |
Plasmid | pGBKT7 | 100 ng/μL | 20 μL |
Plasmid | pGADT7-largeT | 100 ng/μL | 20 μL |
Plasmid | pGBKT7-p53 | 100 ng/μL | 20 μL |
Plasmid | pGBKT7-laminC | 100 ng/μL | 20 μL |
Strain | AH109 | Inoculated Plate | 1 plate |
Strain | Y187 | Inoculated Plate | 1 plate |
Strain | Y2HGold | Inoculated Plate | 1 plate |
Primer | AD-R | Lyophilized | 2 OD |
Primer | T7-F | Lyophilized | 2 OD |
Primer | BD-R | Lyophilized | 2 OD |
Why Choose This Kit
Comprehensive Components: Includes all essential strains, plasmids, and primers.
Flexible Applications: Supports both cotransformation and mating methods.
Reliable Controls: Includes positive and negative controls for experimental accuracy.
User-Friendly Design: Detailed experimental guidelines and troubleshooting support provided.
이 키트를 선택해야 하는 이유
포괄적인 구성 요소: 실험에 필요한 모든 필수 균주, 플라스미드, 프라이머를 포함합니다.유연한 적용성: 공동 형질전환(co-transformation) 및 교배(mating) 방식을 모두 지원하여 다양한 워크플로우에 적합합니다.신뢰할 수 있는 대조군: 실험의 정확성을 보장하기 위해 양성 및 음성 대조군을 포함합니다.사용자 친화적 설계: 상세한 실험 지침과 문제 해결 지원을 제공합니다."Jena Bioscience는 생화학 연구를 위한 최고의 제품을 제공합니다. 고품질의 실험 도구, 효소 및 화합물을 통해 실험 효율성을 높이고 결과를 향상시킬 수 있습니다. Jena Bioscience와 함께 연구 성공을 경험하세요."